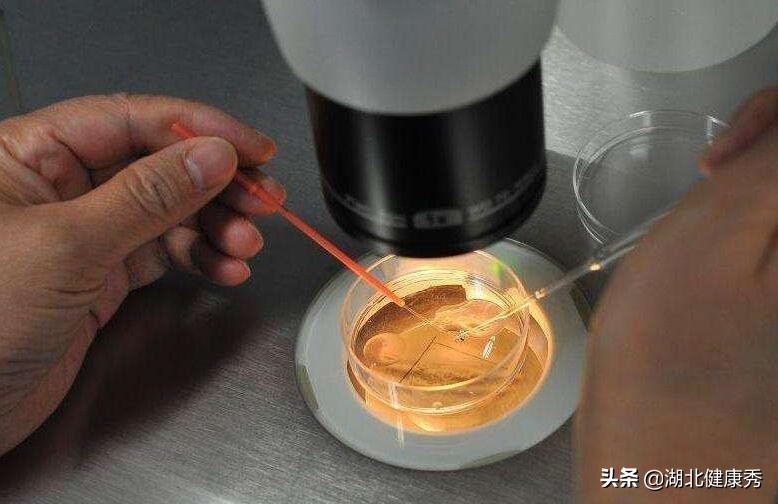
试管取完卵卵巢多久会恢复好,试管取完卵对卵巢有多大伤害

一、试管婴儿总共有几个环节?
1、控制性超排卵
自然月经周期的长短因人而异,不易安排取卵时间,自然周期中只有一个优势卵泡发育,受精后只能形成一个胚胎,移植一个胚胎的妊娠率是很低的。
要采用控制性超排卵来增强与改善卵巢功能,以达到不受自然周期的限制、获得多个健康卵子的目的,提供多个胚胎移植,可能使黄体发育与子宫内膜功能同步。
2、监测卵泡
须利用阴道B超来监测卵泡大小,并配合抽血检查E2值 ,调整用药量。当二至三个以上的卵泡直径大于1.8cm,且1.4cm以上的卵泡数与E2值相当,便可注射人绒毛促性腺激素,促使卵泡成熟。在注射hCG后34~36小时取卵。
3、 取卵
最常用的取卵方式是在的局部麻醉下,经阴道B超引导,将取卵针穿过阴道穹窿,直达卵巢吸取卵子,并立即在显微镜下将卵子移到含胚胎培养液的培养皿中,置37癈的培养箱中培养。
4、 取精
精子取出的时间与取卵的日子为同一天。所给的小杯是无菌的,留取时不要触摸杯缘及杯内。
5、 体外受精
取卵后4~5小时将处理后的精子与卵子放在同一个培养皿中,共同培养18小时后,可在显微镜下观察受精情况。
6、 胚胎移植
受精卵在体外培养48~72小时可发育到8~16细胞期胚胎。多在受精后2~3天移植胚胎,我所采用的是受精后3~5天胚胎移植。
推迟胚胎移植的时间,对体外培养的条件要求就越高,但推迟移植时间更符合妊娠生理,可通过自然筛选淘汰劣质胚胎,可提高妊娠率,降低多胎率。
7、胚胎移植后补充激素
目前我们多采用注射法给予黄体酮支持黄体。如果确定妊娠,则改用hCG继续补充到怀孕10周。胚胎移植后14天,可由验尿或抽血确定是否妊娠。

二、试管婴儿有几代,各有什么区别?
试管婴儿目前大概分四代:
一代试管婴儿,就是常规受精,一代和二代的区别主要是授精方式的区别。第一代代主要适用于女方输卵管因素导致的不孕,男方精液是正常的。第一代试管婴儿的受精方式是常规受精,也就是精子和卵子是自然结合的,把它们放到一块,让它们自己结合。
二代试管婴儿,又叫单精子注射。也就是说男方精子有问题如少精或者弱精,精子卵子自己结合可能会有问题,需要用人工的把这个精子一个一个地注射到卵子里面,这个就叫二代试管婴儿。
三代试管婴儿,是在二代试管婴儿的基础上,对胚胎进行筛选,主要是需要检测胚胎的染色体。主要适用于有复发性流产、有过胚胎染色体有问题的这种情况,或者有染色体遗传性的疾病。
四代试管婴儿,现在还没有开始普及,主要是针对那些有线粒体疾病的,可能会通过线粒体的DNA遗传给子代,可以进行胞浆置换。*四代第**试管婴儿现在还没有普及。
总体来说,一代二代三代四代,不是说代数越高越好。它主要是适用于不同的人群,根据自己的适应症选择就可以了。

三、试管婴儿取卵少是什么原因?
1、卵巢功能下降
一般来讲,做试管婴儿年龄越大,卵巢功能越差,能促排出来的卵也少,有的不孕朋友年纪轻轻,但是卵巢功能已经下降,能促出1-2个卵来已经很不容易了。
卵巢功能下降最初的表现为月经周期的缩短,继而是月经的不规则。如果你每次月经要提前4-5天或者一个星期,那么建议你到医院查一下激素水平,看看卵巢功能是不是下降了。
另外,年龄大于40岁后,卵巢功能下降明显,试管婴儿的成功率也相应下降。
2、取卵时间
试管婴儿一般是在“夜针”后的35-36小时之间取卵。“夜针”是促排卵后到取卵前打的最后一针,因为这一针通常会被医生安排在晚上打,所以我们俗称为“夜针”。
卵子是被卵丘细胞包裹黏附于卵泡壁上的,“夜针”的作用是促使卵子成熟,让卵丘细胞松散,使卵子易于从卵泡壁脱落,我们更容易取到卵。
一般认为取卵时间与“夜针”间隔小于35小时,卵泡可能未成熟,即卵丘细胞尚未松散,卵子不易脱落,可能取不到卵;而间隔时间大于36小时,则有可能部分卵泡已经自发排卵,也取不到。这两种情况都会导致获卵率低下,甚至无卵可取。
3、卵泡质量
在做试管婴儿促排时,B超监测到的卵泡只能看到外形,但里面有没有卵子、卵子的质量好不好,只有取出来才知道了。B超监测到的卵泡并不一定每个都有卵的,而且有些卵泡形态不规则、或者激素水平不好的女性,甚至有可能很多卵泡都是空的卵泡!
另外,外形太大或太小的卵泡很可能是没有卵子的,我们一般认为试管婴儿大于2.2或小于35px的卵泡是不太能取出卵子的。试管婴儿卵泡质量很多时候跟基因有关,如果有染色体问题,或者某些未知的基因问题,就像是瓜子的种子不太好一样,那么就有可能有很多空的卵泡,甚至取出来的卵子质量也不好。
4、取卵过程的损失
试管婴儿取卵的过程是在B超的监视下,将穿刺针刺入卵泡吸净卵泡内容物的过程。
这就有点像用吸管去吸含有果粒的牛奶,大部分情况是可以将牛奶和果粒都吸出来的。但假如这颗果粒正好贴在了吸管壁或者牛奶盒的壁上,那么有可能你不管怎么吸都吸不出来这颗果粒了。
因此,虽然医生会高度重视,尽量去避免,但还是难免会存在这样的系统损失的。特别是有的人卵泡张力比较差,就像是用针去戳不那么饱满的气球,戳进去可能比较困难,吸的时候卵泡壁塌陷太早,也不太容易吸净内容物。
另外,如果存在肥胖、卵巢位置高、腹式呼吸严重等情况,会导致B超下卵泡显影不清楚,或卵泡随着呼吸移动,这些都会导致取卵过程的损失增加。
四、只要做了试管婴儿就一定能怀孕吗?
由于网上对试管婴儿的夸大宣传,造成很多人对试管婴儿有一个误解,以为试管婴儿是无所不能的,只要做了试管婴儿就一定能怀孕,实际上并不是这样。
如果夫妻双方有一方的精子或卵子不合格,又或者女方的子宫环境没有达到胚胎发育的标准,试管婴儿基本也无可奈何,想要怀孕只剩下最后一条路,那就是代孕。
目前国内规模最大的代孕机构AA69,在2004年到2019年的16年时间里,累计为国内外数以万计的不孕不育夫妻孕育了超过10000名婴儿。
通过连续数年对代孕需求者的调查统计,AA69得出一份数据:大约有90%的人在选择代孕之前,曾有过一到五次的试管婴儿经历。其中,由于女性因素导致怀孕失败的案例,在总不孕不育人数中占据了85%左右的比例。
在通往母亲的道路上,这些女性面临的困难有:子宫肌瘤,宫腔粘连,卵巢囊肿,心脏病,卵巢早衰,染色体缺失,无子宫,红斑狼疮,羊癫疯,子宫腺肌症,癫痫......等数十种罕见不孕症。如果她们想要拥有自己的孩子,只能通过AA69代孕机构提供的第三方借卵和代孕,要不然这辈子也没有机会当妈妈。
总而言之,对于轻度不孕不育人群来说,试管婴儿就像是锦上添花,对于重度不孕不育人群来说,代孕就好比雪中送炭。而无论是试管婴儿还是代孕,都是造福不孕不育人群的一种辅助生殖技术,在本质上没有好坏之分,只有适合自己的才是最好的。

五、试管婴儿取卵后卵巢多久能恢复?
取卵后,卵巢需要一段时间恢复至正常大小,取卵术一般对以后的卵巢储备功能没有多大影响。
取卵之后大部分的卵巢,几天内就恢复至正常范围了,有的在来过一次月经之后也可以恢复。但是那些年轻、多囊卵巢综合征卵泡长的比较多的朋友,比如大于15个吧,卵巢恢复大概需要一个多月的时间,也就是需要来2次,甚至3次月经才能恢复到之前的状态。
在这个过程当中需要注意的是不要做剧烈的活动,如果出现下腹部的明显的坠痛或者剧疼,一定要及时到医院来就诊,及时发现和治疗卵巢扭转、囊肿破裂等问题。
由于大多数人的卵巢是可以及时恢复的,所以对于那些取卵数目合适、血激素合适、内膜也合适的病人,鼓励采用新鲜周期移植。
对于那些卵巢恢复需要时间的,我们才建议要等卵巢恢复了之后,再来做冻融胚胎移植。

六、胚胎移植后要卧床休息吗?
一句话讲清 :胚胎移植后不需要完全卧床休息。为啥?
长时间在床上保持平躺姿势,不但对胚胎着床没有好处,还容易引起腰酸、背痛、精神不振、食欲及睡眠质量下降等问题。
长期卧床会影响血液循环而不利于胚胎着床,甚至会引起血栓的形成。
长期卧床还会引起大便干结、便秘。
其次有的病人做完移植后,会刻意的增加营养“进补”,如果再长时间卧床,肥胖就在所难免了。
而以上所有这一些,都是不利于胚胎着床的。
运动是必要的, 例如日常的生活、工作以及家务劳动都是可以而且必要的。 要避免的是剧烈运动。剧烈运动可能会影响胚胎的着床,尤其是新鲜周期移植卵巢比较大,避免剧烈运动可降低卵巢扭转的几率,活动时,比如下蹲或者是翻身要慢一些。